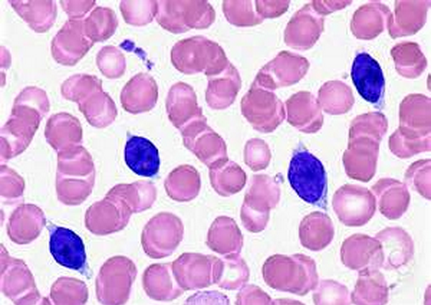

脾边缘区淋巴瘤是一种罕见的癌症,其通常发病非常缓慢,而且患者仅在医生认为需要治疗的时候才开始进行治疗,该病在所有的淋巴瘤患者中占到了3%,目前对该病的发病机理研究非常少。Jonathan Strefford教授说道,通过揭示和该病不良预后相关的遗传表现,医生们就可以确定哪些患者会发生恶性的癌症,以及哪些患者在疾病早期需要进行高剂量的药物或疗法来进行治疗。
文章中,研究者首次揭示了和脾边缘区淋巴瘤相关联的基因缺陷,其可以影响患者的预后情况;癌细胞中TP53基因的错误被认为是诱发癌症的原因,KLF2和NOTCH2基因缺陷的存在同时也揭示了病人需要快速进行集中性的治疗。
理解不同遗传改变任何引发患者发病将可以帮助研究人员设计出新型的疗法来帮助治疗多种不同的血癌,但是截止到目前研究人员对于脾边缘区淋巴瘤却束手无策,而本文研究或将帮助医生和病人们更多地了解该病的发病,以及帮助研究者开发有效改善脾边缘区淋巴瘤患者症状的潜在疗法。



